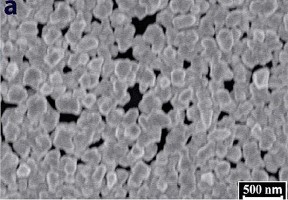
Hình 3 1 Ảnh SEM của AuNP trên bề mặt GCE được xử lý bằng các kỹ thuật 4
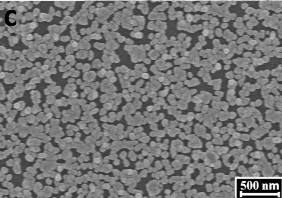
Hình 3 1 Ảnh SEM của AuNP trên bề mặt GCE được xử lý bằng các kỹ thuật 6

Hình ảnh bề mặt điện cực trước và sau khi tạo lớp vàng nano được thể hiện trên hình 2.2.
2.2.2. Chế tạo các SAM biến tính lớp AuNP trên điện cực GCE
2.2.2.1. Chế tạo SAM 4-pyridinethanthiol (PET-SAM)
GCE sau khi đã được điện kết tủa AuNP trên bề mặt được ngâm trong dung dịch PET được pha trong dung môi etanol tuyệt đối ở nhiệt độ phòng. Điện cực sau khi chế tạo xong được ký hiệu là PET-SAM/AuNP/GCE [161].
2.2.2.2. Chế tạo SAM 2-aminoethanethiol (AET-SAM)
Tương tự điện cực biến tính bởi PET-SAM, điện cực GCE sau khi đã được điện kết tủa AuNP trên bề mặt được ngâm trong dung dịch AET pha trong dung môi etanol tuyệt đối ở nhiệt độ phòng. Điện cực sau khi chế tạo xong được ký hiệu là: AET-SAM/AuNP/GCE.
2.2.2.3. Chế tạo SAM hai cấu tử (PET-AET- SAM)
Điện cực sau khi biến tính bởi PET-SAM được ngâm trong dung dịch AET ở nồng độ và thời gian ngâm khác nhau được được khảo sát. Điện cực sau khi chế tạo xong được ký hiệu là: PET-AET-SAM/AuNP/GCE.
Cuối cùng, các điện cực sau khi biến tính được rửa với nước cất và cồn tuyệt đối.
2.2.3. Chế tạo lớp composit AuNP-GO trên điện cực GCE
Điện cực GCE sau khi được mài bóng, làm sạch và hoạt hóa được điện phân trong dung dịch hỗn hợp HAuCl4 1,0 10-3 M + GO (gọi tắt là dung dịch AuNP • GO) bằng cách áp thế 0,5 V trong điều kiện có khuấy.
Ảnh hưởng của nồng độ GO, pH của dung dịch AuNP • GO, thời gian điện phân được khảo sát.
Sau đó, rửa sạch điện cực bằng nước cất và cồn tuyệt đối, để khô trong không khí trước khi sử dụng. Điện cực sau chế tạo được ký hiệu là AuNP • GO.
2.2.4. Chế tạo các SAM biến tính lớp composit AuNP-GO trên điện cực GCE
2.2.4.1. Chế tạo PET-SAM
GCE sau khi đã được điện kết tủa AuNP+GO trên bề mặt được ngâm trong dung dịch PET ở nồng độ và thời gian khảo sát ở nhiệt độ phòng để tạo PET-SAM. Sau đó,
điện cực được rửa sạch bằng dung dịch ethanol để loại bỏ lượng PET còn dư trên bề mặt. Điện cực sau khi chế tạo xong được ký hiệu là: PET-SAM/AuNP+GO.
2.2.4.2. Chế tạo AET-SAM
Tương tự điện cực biến tính bởi PET-SAM, điện cực GCE sau khi đã được điện kết tủa AuNP-GO trên bề mặt được ngâm trong dung dịch AET ở nhiệt độ phòng. Điện cực sau khi chế tạo xong được ký hiệu là AET-SAM/AuNP.
Điện cực sau khi biến tính bởi PET-SAM được ngâm trong dung dịch AET ở nồng độ và thời gian ngâm khác nhau đã được khảo sát. Điện cực sau khi chế tạo xong được ký hiệu là PET-AET-SAM/AuNP-GO.
2.3. Phương pháp nghiên cứu
2.3.1. Các phương pháp nghiên cứu đặc trưng vật liệu
2.3.1.1. Phương pháp kính hiển vi điện tử quét (SEM)
Hình thái cấu trúc lớp AuNP và AuNP-GO được nghiên cứu bởi thiết bị chụp ảnh hiển vi điện tử quét (SEM) S-4800 (Hitachi, Nhật Bản) với chùm điện tử sơ cấp được gia tốc bằng điện thế từ 15-20 kV khoảng cách 4-5mm, trong các trường hợp:
- Bề mặt AuNP với thời gian điện phân kết tủa vàng: 50 giây, 300 giây, 600 giây.
- Bề mặt AuNP • GO với thời gian điện phân kết tủa tối ưu: 600 giây.
2.3.1.2. Phương pháp nhiễu xạ tia X (XRD)
- Cấu trúc lớp AuNP được nghiên cứu bằng phương pháp nhiễu xạ tia X (XRD) chụp trên thiết bị D8AVVACE (Khoa Hóa học, Trường Đại Học Khoa Học Tự Nhiên, Đại Học Quốc Gia Hà Nội), ống phát tia CuK(=1,54056 Å), cường độ dòng ống phát 40 mA, góc quét 2θ từ 10o đến 85o, tốc độ quét 0,2o/phút.
2.3.1.3. Phương pháp hồng ngoại (FTIR)
Nghiên cứu cấu trúc vật liệu composit được tiến hành đo phổ hồng ngoại biến đổi Fourier (Fourier transform infrared spectroscopy-FTIR). Các phép đo được tiến hành trên thiết bị FTIR-6300 (Khoa Hóa học, Trường Đại Học Khoa Học Tự Nhiên, Đại Học Quốc Gia Hà Nội) ở áp suất khí quyển, độ phân giải 4 cm-1, với góc tới 450.
2.3.2. Phương pháp phân tích đối chứng AAS
Độ chính xác của phương pháp và các kết quả phân tích lượng vết thủy ngân trong mẫu thật được đánh giá so sánh với các kết quả đo bằng phương pháp quang phổ hấp thụ nguyên tử hóa hơi lạnh (AAS).
2.3.3. Các phương pháp đo điện hóa
Các phép đo điện hóa được sử dụng để nghiên cứu các hoạt tính điện hóa cũng như khả năng phân tích của các điện cực đã chế tạo
2.3.3.1. Nghiên cứu khử hấp phụ
Khử hấp phụ lớp SAM của AET, PET và PET AET được thực hiện bằng phép quét thế vòng điện cực trong dung dịch KOH 0,5 M đã được loại bỏ oxi hoà tan bằng cách sục khí N2 trong thời gian 15 phút. Khoảng thế quét từ U1 = 0,00 V đến U2 = - 1,30 V, tốc độ quét thế là 0,1 V/s. Kết quả của phép đo sẽ cho thông tin về khả năng hấp phụ của các phân tử hợp chất hữu cơ AET hoặc PET trên điện cực.
2.3.3.2. Khảo sát độ thuận nghịch của phản ứng điện hóa trên các điện cực đã chế tạo Điện cực được nghiên cứu trên hệ điện hóa đơn giản của cặp oxi hóa – khử Fe(III)/Fe(II) bằng phương pháp quét thế vòng, tốc độ quét 0,1 V/s, khoảng thế quét từ -0,025 V đến 0,45 V. Dung dịch điện li sử dụng trong nghiên cứu này là dung dịch
K3[Fe(CN) 6] 0,5 M pha trong đệm photphat (PBS) 0,1 M, pH = 7.
2.3.3.3. Phân tích thủy ngân bằng các điện cực biến tính SAM chế tạo
Các điện cực biến tính SAM sau khi chế tạo được sử dụng phân tích Hg (II) với phương pháp phân tích phát hiện và điểu kiện đo như sau:
Phương pháp phân tích phát hiện Hg(II) được thực hiện qua hai bước như sau:
*Bước 1: Hg (II) được làm giàu lên bề mặt điện cực WE đã biến tính với các SAM bằng cách ngâm hấp phụ hóa học điện cực làm việc trong dung dịch chứa ion Hg(II) trong môi trường pH = 7, với các thời gian ngâm được khảo sát: 5 phút, 10 phút, 30 phút, 80 phút, 100 phút, 120 phút, 150 phút, 180 phút, 200 phút trong điều kiện có khuấy với tốc độ 60 vòng/phút.
*Bước 2: Việc phân tích phát hiện lượng vết Hg (II) sau khi làm giàu được thực hiện bằng phương pháp Von-Ampe xung vi phân với hai kỹ thuật quét được khảo sát: quét theo chiều catot và quét theo chiều anot.
Các điều kiện đo phân tích phát hiện Hg (II):
Đo tín hiệu điện hóa trong dung dịch KCl 0,1 M + HCl pH = 3 với độ lớn xung là 50 mV, thời gian phát xung 0,04 giây, bước nhảy xung 5 mV với thời gian 0,08 giây, tốc độ quét xung 50 mV/giây. Các phép đo điện hóa được tiến hành ở nhiệt độ phòng (25oC ± 1).[162]
2.3.3.4. Khảo sát ảnh hưởng của các cation và anion
Khảo sát ảnh hưởng của các cation: Cu2+, Pb2+, Zn2+, Cd2+, Fe3+, Ni2+, Mn2+ và các anion: Cl-, NO3-, SO42-.
Đo mẫu Hg(II) 1 ppb.
Đo mẫu Hg (II) 1 ppb có mặt đồng thời các cation và anion với nồng độ tăng dần.
2.3.3.5. Xây dựng đường chuẩn
Tiến hành xây dựng đường chuẩn trong khoảng nồng độ tuyến tính trên từng điện cực được chế tạo. Các mẫu nước Hg (II) có nồng độ khác nhau đã được sử dụng để đo sự thay đổi chiều cao píc Hg (II) sử dụng phương pháp DPASV. Dãy các dung dịch chuẩn Hg (II) được pha từ dung dịch chuẩn gốc có nồng độ 1000 ppm đã được chuẩn bị để đo trên các điện cực khác nhau:
Đối với điện cực PET-SAM/AuNP dãy các dung dịch chuẩn Hg (II) được chuẩn bị có nồng độ lần lượt là: 100 ppt, 300 ppt, 500 ppt, 800 ppt, 1000 ppt.
Đối với điện cực PET-AET-SAM/AuNP dãy các dung dịch chuẩn Hg (II) được chuẩn bị có nồng độ lần lượt là: 50 ppt, 100 ppt, 300 ppt, 600 ppt, 800 ppt, 1000 ppt, 1500ppt, 1800 ppt, 2000 ppt.
Đối với điện cực PET-AET-SAM/AuNP-GO dãy các dung dịch chuẩn Hg (II) được chuẩn bị có nồng độ lần lượt là: 30 ppt, 100 ppt, 300 ppt, 500 ppt, 800 ppt, 1000 ppt, 2000 ppt, 3000 ppt, 3500 ppt.
Các dung dịch được chuẩn bị trong môi trường pH=7. Lấy 40 ml dung dịch chuẩn cho vào ống đong và ngâm hấp phụ các điện cực được chế tạo trong thời gian 30 phút. Dung dịch đo là KCl 0,1M + HCl pH=3.
Đường chuẩn được xây dựng từ các điều kiện tối ưu đã được khảo sát.
2.4. Phân tích mẫu thực
2.4.1. Lấy mẫu và bảo quản mẫu
Với mục đích kiểm tra tính năng của điện cực chế tạo trong việc phân tích phát hiện Hg (II), các mẫu nước được lấy và bảo quản theo TCVN [163]. Mẫu thực tế lấy để phân tích bao gồm:
- Mẫu nước sông Tô Lịch được lấy tại đoạn giao với đường Hoàng Quốc Việt ở tọa độ 21o 2’ 45.4” N; 105o 48’ 19.4” và bảo quản theo TCVN 5993: 1995; TCVN
6663-6:2008.
- Mẫu nước biển Hải Tiến, biển Lạch Vạn được lấy tại vị trí không có xự xả thải trực tiếp nước thải công nghiệp, nước thải sinh hoạt và bảo quản theo TCVN 5993: 1995; TCVN 5998:1995.
- Mẫu nước thải nhà máy bóng đèn phích nước Rạng Đông được lấy bể thải đã qua xử lý và bảo quản theo TCVN 5993: 1995, TCVN 5999:1995.
Các mẫu nước sau khi lấy về phòng thí nghiệm được axit hóa bằng HNO3, pH=2. Với các mẫu nước đục được xử lý bằng cách lọc loại bỏ các chất rắn lơ lửng, nước được bảo quản 1 tháng trong chai PP.
2.4.2. Tiến trình phân tích
Hút 40 ml nước sau khi đã xử lý cho vào cốc thủy tinh có dung tích 100 ml, điều chỉnh pH dung dịch đến pH=7 bằng dung dịch NaOH 0,1M. Ghi đo dòng DPASV theo phương pháp thêm chuẩn với điều kiện ghi đo: áp thế -0,4 V trong thời gian 60 giây, sau đó quét thế theo chiều anot từ 0,35 V đến 0,66 V với tốc độ quét v =0,1 V/s, độ lớn xung là 50 mV, thời gian phát xung 0,04 giây, bước nhảy xung 5 mV với thời gian 0,08 giây, tốc độ quét xung 50mV/giây trong dung dịch KCl 0,1 M + HCl, pH=3.
2.5. Phương pháp thống kê và phần mềm xử lý số liệu thực nghiệm
Các giá trị chiều cao píc, thế đỉnh píc trên các đồ thị của phép đo điện hóa được tính toán bằng phần mềm tương ứng với từng phép đo: PGSdynam và DPP.
Việc xử lý thống kê, tính toán độ lặp lại của phép phân tích Hg (II) trên các điện cực đã chế tạo được thực hiện bằng phần mềm Excel 2007
- Xác định độ lặp lại dựa trên giá trị độ lệch chuẩn:

Trong đó: +) Phương sai của mẫu:

+) Giá trị trung bình:
(2.1)
(2.2)

(2.3)
- Xử lý các số liệu thực nghiệm và xây dựng đường chuẩn theo phần mềm Origin 8.0. Phương trình hồi quy tuyến tính được thiết lập dưới dạng:
y = (a ± t.Sa) + (b ± t.Sb).x
CHƯƠNG 3. KẾT QUẢ VÀ THẢO LUẬN
3.1. Tạo AuNP trên bề mặt GCE
Để tăng số phân tử tạo SAM trên bề mặt điện cực, bề mặt GCE sẽ được phủ bởi lớp AuNP để không chỉ quá trình hình thành SAM được diễn ra thuận lợi theo cơ chế hấp phụ hóa học, mà hơn nữa, sẽ làm tăng diện tích hoạt động của bề mặt điện cực. Điều này rất có ý nghĩa trong việc làm tăng độ nhạy phát hiện Hg(II).
Để phủ AuNP lên bề mặt GCE thì các yếu tố ảnh hưởng đến quá trình phủ lớp vàng đã được nghiên cứu khảo sát như trình bày dưới đây.
3.1.1. Các kỹ thuật điện hóa hoạt hóa bề mặt GCE
Bên cạnh xử lý cơ học bề mặt GCE như sử dụng giấy nhám, siêu âm thì bước hoạt hóa điện cực cũng rất quan trọng trong việc hình thành lớp AuNP, và do đó ảnh hưởng đáng kể đến chất lượng SAM được thực hiện ở bước tiếp theo.
Để đánh giá sự ảnh hưởng của việc hoạt hóa bề mặt GCE đến hình thái lớp vàng được điện kết tủa trên bề mặt, các kỹ thuật hoạt hóa điện hóa bề mặt GCE trong dung dịch H2SO4 0,5 M đã được khảo sát với các điều kiện áp thế khác nhau:
(i) GCE được phân cực anot tại thế + 0,8 V trong 300 giây (ký hiệu PP1),
(ii) Phân cực anot tại thế + 0,8 V trong 300 giây sau đó phân cực catot tại thế -1 V trong 300 giây (ký hiệu PP2),
(iii) Phân cực catot tại thế -1 V trong 300 giây sau đó phân cực anot tại thế +0,8 V trong 300 giây (ký hiệu PP3),
(iv) Phân cực catot tại thế -1 V trong 300 giây (ký hiệu PP4).
Sự khác nhau về hình thái lớp AuNP được tạo thành trên bề mặt GCE sau khi điện cực đã được được xử lý bằng PP1÷PP4 được trình bày trên hình 3.1. Kết quả cho thấy khi bề mặt GCE được hoạt hóa bằng PP4 thì kích thước hạt vàng khá đồng đều và có kích thước cỡ 90 nm. Sự sắp xếp của hạt vàng có kích thước nano mét này đã tạo nên một lớp che phủ gần như kín bề mặt GCE. Kết quả còn cho thấy sự xếp chồng của các hạt là không đáng kể so với PP1 và PP3. Kích thước hạt vàng trung bình ước tính của các phương pháp là: PP1: 220 nm, PP2: 175 nm, PP3: 120 nm, PP4: 90 nm. Kết qủa này cho thấy rò điều kiện hoạt hóa của PP4 thuận lợi cho sự hình thành các hạt vàng ở kích thước nano mét. Vì vậy, PP4 đã được lựa chọn để hoạt hóa
bề mặt GCE trước khi phủ AuNP.

Hình 3. 1. Ảnh SEM của AuNP trên bề mặt GCE được xử lý bằng các kỹ thuật điện hóa khác nhau: PP1 (a), PP2 (b), PP3 (c), PP4 (d)
3.1.2. Các điều kiện điện phân tạo AuNP
٭ Ảnh hưởng của thời gian điện phân tạo AuNP
Sự phụ thuộc của mật độ và kích thước của các hạt vàng được tạo trên trên bề mặt điện cực GCE vào thời gian điện phân được đánh giá thông qua các ảnh SEM như trình bày trên hình 3.2. Kết quả thu được cho thấy mật độ các hạt AuNP trên bề mặt GCE tăng tỉ lệ theo thời gian điện phân khi áp thế cố định +0,5 V. Ở thời gian 50 giây các hạt vàng bắt đầu xuất hiện và nằm rải rác trên bề mặt GCE (hình 3.2 (a)). Khi tăng thời gian điện phân lên 300 giây có sự tăng lên về số lượng các mầm tinh thể vàng do đó mật độ các hạt vàng đã dày đặc hơn nhưng chưa phủ kín hết bề mặt GCE (hình 3.2 (b)). Khi tăng thời gian điện phân lên 600 giây, các hạt vàng đã phủ gần như kín bề mặt GCE, kích thước các hạt vàng thu được khá đồng đều và được sắp xếp sát nhau tạo thành lớp phủ kín bề mặt GCE (hình 3.2 (c)).
|
Có thể bạn quan tâm!
-
Ảnh Sem Graphen Được Chế Tạo Bằng Phương Pháp Cvd [98]. -
Ảnh Sem Các Điện Cực Aunp Được Chế Tạo Bằng Các Phương Pháp Khác Nhau: Áp Thế Cố Định (A) [117], Quét Thế Vòng (B) [120], Hấp Phụ Hóa Học (C) [ -
(A) Sự Biến Thiên Thế Theo Thời Gian, (B) Dạng Đường Von-Ampe Hòa Tan Trong Kỹ Thuật Von-Ampe Xung Vi Phân. -
Ảnh Sem Của Aunp Trên Bề Mặt Điện Cực Gce Với Thời Gian Tạo Vàng Khác Nhau: 50 Giây (A), 300 Giây (B), 600 Giây (C) -
Diện Tích Hoạt Động Điện Hóa Của Điện Cực Aunp/gce Và Aunp- Go/gce -
Cơ Sở Lý Thuyết Sử Dụng Sam Biến Tính Điện Cực Phân Tích Hg (Ii)



![Ảnh Sem Graphen Được Chế Tạo Bằng Phương Pháp Cvd [98].](https://tailieuthamkhao.com/uploads/2022/07/13/nghien-cuu-bien-tinh-dien-cuc-than-thuy-tinh-bang-vat-lieu-co-cau-truc-nano-5-1-120x90.jpg)
![Ảnh Sem Các Điện Cực Aunp Được Chế Tạo Bằng Các Phương Pháp Khác Nhau: Áp Thế Cố Định (A) [117], Quét Thế Vòng (B) [120], Hấp Phụ Hóa Học (C) [](https://tailieuthamkhao.com/uploads/2022/07/13/nghien-cuu-bien-tinh-dien-cuc-than-thuy-tinh-bang-vat-lieu-co-cau-truc-nano-6-1-120x90.jpg)



